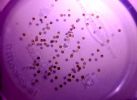

Fundulopanchax gardneri gardneri (Gardneri Killifish - Yıllık Balığı) Fundulopanchax Gardneri

28/08/2025 16:34:57

28/08/2025 16:49:05

29/08/2025 19:38:22

31/08/2025 23:04:23

31/08/2025 23:14:38

31/08/2025 23:20:38

01/09/2025 12:53:38

05/09/2025 20:08:28

07/09/2025 16:06:04

15/09/2025 02:33:57

15/09/2025 02:47:22

16/09/2025 06:39:41

17/09/2025 13:41:26

17/09/2025 21:49:37

23/09/2025 15:57:04

23/09/2025 16:00:49

29/09/2025 14:31:58

05/10/2025 20:56:16

20/10/2025 14:35:55

20/10/2025 14:59:11

22/10/2025 21:43:46

08/12/2025 21:04:00

23/03/2026 17:31:53

11/04/2026 23:16:21

17/09/2025 13:55:12

17/09/2025 13:55:12

11/04/2026 23:16:21

23/03/2026 17:31:53

20/10/2025 14:35:55

05/10/2025 20:56:16

29/09/2025 14:31:58

23/09/2025 16:00:49

17/09/2025 13:41:26

16/09/2025 06:39:41

07/09/2025 16:06:04

31/08/2025 23:14:38

31/08/2025 23:04:23

29/08/2025 19:38:22

28/08/2025 16:49:05

28/08/2025 16:34:57

29/08/2025 19:38:22

31/08/2025 23:14:38

07/09/2025 16:06:04

16/09/2025 06:39:41

17/09/2025 13:41:26

23/09/2025 16:00:49

29/09/2025 14:31:58

05/10/2025 20:56:16

20/10/2025 14:35:55

23/03/2026 17:31:53

11/04/2026 23:16:21

11/04/2026 23:16:21

20/10/2025 14:35:55

05/10/2025 20:56:16

29/09/2025 14:31:58

23/09/2025 16:00:49

17/09/2025 13:41:26

16/09/2025 06:39:41

29/08/2025 19:38:22

29/09/2025 14:31:58

05/10/2025 20:56:16

20/10/2025 14:35:55

20/10/2025 14:35:55

05/10/2025 20:56:16

29/09/2025 14:31:58

20/10/2025 14:35:55
Açıklama:
Paylaşımınız için teşekkürler ama uzun süre farklı türlerde killifish beslemiş bir hobici olarak ben de bazı tecrübelerimi paylaşmak isterim. Sizin tanıtımını yapmış olduğunuz gardneri Batı Afrika çok yıllık killifish ailesinden Fundulopanchax cinsi içerisinde. Bu cinse mensup türler killifish yetiştiricileri arasında genelde kürek ağızlı olarak adlandırılır. Bunun sebebi görüntüde normal olan ağzı çok geniş bir şekilde açılabiliyor. Bu nedenle tank arkadaşı olarak yazdığını türlerden ağzına sığan yavrular, genç bireyler ya da doğrudan küçük boyutlu olan türleri net bir şekilde yemeye çalışacaktır. Karides konusunda da Afrika vampir karidesi ya da Asya bambu karidesi gibi dev türler haricinde yavru - yetişkin ayırt etmeksizin keyifle avlayacaktır. Buna ek olarak uzun kuyruklu balıklar ya da yavaş hareket eden her türlü balığı da finlerinden taciz edecektir. Bu nedenle çoğunlukla killifish türleri tek tür olarak bakılır. İdeal bir tank arkadaşı arıyorsak Pelvichromisler gibi Africa cüce cichlidleri ve iri Asya barbları benim tavsiyem olur.
Tanıtımınızda anaçlarınızın da fotoğraflarını görmeyi çok isterim açıkçası. Ülkemizde bir iki tür ithalat listelerinde yer alıyor. Gümrük vergileri ve PayPal'ın durumundan dolayı maalesef eskisi gibi yurtdışından yumurta satın alamıyoruz. O yüzden iyiden iyiye azalan killifishleri besleyip ürettiğiniz için çok teşekkür ederim.
Paylaşımınız için teşekkürler ama uzun süre farklı türlerde killifish beslemiş bir hobici olarak ben de bazı tecrübelerimi paylaşmak isterim. Sizin tanıtımını yapmış olduğunuz gardneri Batı Afrika çok yıllık killifish ailesinden Fundulopanchax cinsi içerisinde. Bu cinse mensup türler killifish yetiştiricileri arasında genelde kürek ağızlı olarak adlandırılır. Bunun sebebi görüntüde normal olan ağzı çok geniş bir şekilde açılabiliyor. Bu nedenle tank arkadaşı olarak yazdığını türlerden ağzına sığan yavrular, genç bireyler ya da doğrudan küçük boyutlu olan türleri net bir şekilde yemeye çalışacaktır. Karides konusunda da Afrika vampir karidesi ya da Asya bambu karidesi gibi dev türler haricinde yavru - yetişkin ayırt etmeksizin keyifle avlayacaktır. Buna ek olarak uzun kuyruklu balıklar ya da yavaş hareket eden her türlü balığı da finlerinden taciz edecektir. Bu nedenle çoğunlukla killifish türleri tek tür olarak bakılır. İdeal bir tank arkadaşı arıyorsak Pelvichromisler gibi Africa cüce cichlidleri ve iri Asya barbları benim tavsiyem olur.
Tanıtımınızda anaçlarınızın da fotoğraflarını görmeyi çok isterim açıkçası. Ülkemizde bir iki tür ithalat listelerinde yer alıyor. Gümrük vergileri ve PayPal'ın durumundan dolayı maalesef eskisi gibi yurtdışından yumurta satın alamıyoruz. O yüzden iyiden iyiye azalan killifishleri besleyip ürettiğiniz için çok teşekkür ederim.
[/QUOTE]
Merhabalar Tolga bey;
Merak edenlerin araştırıp farklı ve faydalı diğer bilgileri de öğrenmesini teşvik etmek maksatlı bilerek çoğu zaman resim eklemiyorum.
Ayrıca tank kurulum ve düzeneklerimi paylaşmakta istemiyorum.
Sizin killifish türleri üzerine zengin bir koleksiyona sahip olduğunuzu biliyorum.
Uzun süredir paylaşım yapmamanız gerek tecrübenizden gerek güzelliklerden bizi mahrum bırakıyor.
[IMG]https://foto.akvaryum.com/fotolar/21182/290820251937441.jpg[/IMG]
[IMG]https://foto.akvaryum.com/fotolar/21182/290820251937451.jpg[/IMG]
[IMG]https://foto.akvaryum.com/fotolar/21182/290820251937461.jpg[/IMG]
6 yavru ilk 30 dk içinde çıkış yaptı.
Heyecan dorukta..
[IMG]https://foto.akvaryum.com/fotolar/21182/310820252301341.jpg[/IMG]
[IMG]https://foto.akvaryum.com/fotolar/21182/310820252301361.jpg[/IMG]
[IMG]https://foto.akvaryum.com/fotolar/21182/310820252313471.jpg[/IMG]
[IMG]https://foto.akvaryum.com/fotolar/21182/310820252313481.jpg[/IMG]
Yumurta çatlama anını videoya almaya çalışıyorum; umarım başarırım.
[IMG]https://foto.akvaryum.com/fotolar/21182/310820252319411.jpg[/IMG]
Sizin killifish türleri üzerine zengin bir koleksiyona sahip olduğunuzu biliyorum.
Uzun süredir paylaşım yapmamanız gerek tecrübenizden gerek güzelliklerden bizi mahrum bırakıyor.
[/QUOTE]
Tekrardan selamlar,
Çok naziksiniz ama ben de sıradan bir hobiciyim. Hem yurtdışından yumurta almanın mümkün olduğu hem de döviz kurları nedeniyle istediğimiz balığı Almanya ya da Çekya ithalatlarına poşet usulü yazdırabildiğimiz bir dönemde maymun iştahımla saldırmıştım. Haliyle pek de sürdürülebilir olmadı benim için. Sonrasında kadar çok türü eş zamanlı besleme şansım da iş hayatımın yoğunluğundan ilgilenecek vaktim de olmadı. Yine de bir kaç türü her zaman besledim. Son bir yıldır balığım yok. Ara ara tekrardan heveslenip beslemeye niyetlensem de artık besleyebileceğim pek tür de yok piyasa da. Bu yüzden sizin gibi hobicilerin paylaşımlarını gördükçe mutlu oluyorum. Umarım bu türü üretip dağıtarak killifish seven hobicileri artırırsınız.
[IMG]https://foto.akvaryum.com/fotolar/21182/050920252007471.jpg[/IMG]
[IMG]https://foto.akvaryum.com/fotolar/21182/070920251604551.jpg[/IMG]
[IMG]https://foto.akvaryum.com/fotolar/21182/070920251604531.jpg[/IMG]
Gece 02.30 halen yumurta topluyorum çay eşliğinde.
Yarın büyük ihtimalle kavaltıda havyar var. [:lol:]
[IMG]https://foto.akvaryum.com/fotolar/21182/160920250637091.jpg[/IMG]
Yumurtalara dokununca patlıyor..[:D]
[IMG]https://foto.akvaryum.com/fotolar/21182/160920250637101.jpg[/IMG]
[IMG]https://foto.akvaryum.com/fotolar/21182/160920250637111.jpg[/IMG]
[IMG]https://foto.akvaryum.com/fotolar/21182/160920250637131.jpg[/IMG]
Lepistes plati Yavrularını gardneriler yiyecektir.
[EDIT]Cyber_Scout,2025-09-16 15:40:13[/EDIT]
Lepistes plati Yavrularını gardneriler yiyecektir.
[/QUOTE]
Onun dışında sıkıntı olur mu bide gardneri gibi killifish türkerini nerden temin ederşm yardımcı olur musunuz
Onun dışında sıkıntı olur mu bide gardneri gibi killifish türkerini nerden temin ederşm yardımcı olur musunuz[/QUOTE]
Bu konunun ilk sayfasında ansiklopedik bilgisini paylaşmıştım.
Muğla Hobihanem de ;
Killifish - Norman's Lampeye
Killifish - Clown (Epiplatys Annulatus)
Killifish - Pancax (Golden) [Aplocheilus Lineatus]
Killifish - Gardneri (Fundulopanchax)
Killifish - Trigonectes Macrophthalmus (Neon Striped)
Killifish - Aphyosemion Australe (Lirkuyruk Killifish)
Killifish - Nothobranchius Guentheri
Çeşitleri bildiğim kadarıyla ellerinde bulunuyor.
Bu konunun ilk sayfasında ansiklopedik bilgisini paylaşmıştım.
Muğla Hobihanem de ;
Killifish - Norman's Lampeye
Killifish - Clown (Epiplatys Annulatus)
Killifish - Pancax (Golden) [Aplocheilus Lineatus]
Killifish - Gardneri (Fundulopanchax)
Killifish - Trigonectes Macrophthalmus (Neon Striped)
Killifish - Aphyosemion Australe (Lirkuyruk Killifish)
Killifish - Nothobranchius Guentheri
Çeşitleri bildiğim kadarıyla ellerinde bulunuyor.
[/QUOTE]
Teşekürler [:)]
[IMG]https://foto.akvaryum.com/fotolar/21182/170920251340021.jpg[/IMG]
[IMG]https://foto.akvaryum.com/fotolar/21182/170920251340051.jpg[/IMG]
[IMG]https://foto.akvaryum.com/fotolar/21182/170920251340091.jpg[/IMG]
[IMG]https://foto.akvaryum.com/fotolar/21182/170920251340111.jpg[/IMG]
Yumurtadan çıkanlar arasında en hızlı büyüyen balıklardan.
Bu sene yapıp kullandığım yumurtlama ortamını ve yeni tasarımını bende balıklarda çok sevdik.
Bu sene yapıp kullandığım yumurtlama ortamını ve yeni tasarımını bende balıklarda çok sevdik.[/QUOTE]
Neyle yaptınız bu yatağı? Yün iplik gibi görünüyor ama anlayamadım.
[IMG]https://foto.akvaryum.com/fotolar/21182/230920251600261.jpg[/IMG]
[IMG]https://foto.akvaryum.com/fotolar/21182/230920251600291.jpg[/IMG]
[IMG]https://foto.akvaryum.com/fotolar/21182/230920251600321.jpg[/IMG]
[IMG]https://foto.akvaryum.com/fotolar/21182/290920251430311.jpg[/IMG]
[IMG]https://foto.akvaryum.com/fotolar/21182/290920251430321.jpg[/IMG]
[IMG]https://foto.akvaryum.com/fotolar/21182/290920251430331.jpg[/IMG]
[IMG]https://foto.akvaryum.com/fotolar/21182/290920251430341.jpg[/IMG]
[IMG]https://foto.akvaryum.com/fotolar/21182/290920251430361.jpg[/IMG]
42 günlük Fundulopanchax Gardneri
Resimler anlık çekilmiştir.
50.gün
[IMG]https://foto.akvaryum.com/fotolar/21182/051020252053211.jpg[/IMG]
Kuyruk renkleri belirginleşti
[IMG]https://foto.akvaryum.com/fotolar/21182/051020252053381.jpg[/IMG]
[IMG]https://foto.akvaryum.com/fotolar/21182/051020252054211.jpg[/IMG]
Cinsiyet ayrımı 30günlükken bile kolayca yapılıyor.
[IMG]https://foto.akvaryum.com/fotolar/21182/051020252054231.jpg[/IMG]
[IMG]https://foto.akvaryum.com/fotolar/21182/051020252054261.jpg[/IMG]
Hızlı büyümek oburluk gerektiriyor
[IMG]https://foto.akvaryum.com/fotolar/21182/051020252054301.jpg[/IMG]
[IMG]https://foto.akvaryum.com/fotolar/21182/201020251434301.jpg[/IMG]
[IMG]https://foto.akvaryum.com/fotolar/21182/201020251434311.jpg[/IMG]
[IMG]https://foto.akvaryum.com/fotolar/21182/201020251435221.jpg[/IMG]
[IMG]https://foto.akvaryum.com/fotolar/21182/201020251435231.jpg[/IMG]
[IMG]https://foto.akvaryum.com/fotolar/21182/201020251435251.jpg[/IMG]
[IMG]https://foto.akvaryum.com/fotolar/21182/201020251435261.jpg[/IMG]
[IMG]https://foto.akvaryum.com/fotolar/21182/201020251458371.jpg[/IMG]
Soylarının devamı için erkekler baskınlık kavgaları yapıyor.
Bol bitkili bir akvaryumda çift yada trio (1e2d) şeklinde bakılmalı.
Ben yavruları farklı tanklara boylarına göre dağıtıyorum.
Kardinal Neon Tetralar, Galaxy Rasboraların olduğu tankta sadece kendi türleri ile 60 günlük yaştan itibaren üreme ve baskınlık tartışmaları yaşıyorlar.
Ancak ölümcül değil.
Aşırı hızlı büyüme kaynaklı ihtiyaçları için çok besin tüketiyor diğer tür balıkların yemlerini de bitiriyorlar.
Zıplama yetenekleri çok iyi ..
Kendi yaşam alanlarının kuruması, farklı dişilere erkeklere ulaşmak için başka bir birikintiye gidebilmelerini sağlayan gelişmiş bir yetenek.
Kavga izlenmesi gereken bir gösteri aslında...
Yavruları yerler (kendi ebeveynleri de yiyiyor) ancak yetişkinlerle sorunları yok..
Palyaço dediğiniz bu mu,
[IMG]https://foto.akvaryum.com/fotolar/21182/221020252143021.jpg[/IMG]
Pseudepiplatys annulatus
Boyu ve yüzme alışkanlığı sebebiyle istisna olabilir.
Yumurtadan büyüttüğüm gardneri yavrularımın ilk yumurtaları...
Bu konuda yazdığım ilk yumurtalardan büyüdüler ve onlar da bana bu yumurtaları verdi..
[IMG]https://foto.akvaryum.com/fotolar/21182/230320261731311.jpg[/IMG]
[IMG]https://foto.akvaryum.com/fotolar/21182/230320261731321.jpg[/IMG]
Karma akvaryumlarda bakılabiliyor mu?Tetra çeşitleri ve 1 çift cüce çikletim var akvaryumumda...Ölçülerim 50x50x50 cm
Karma akvaryumlarda bakılabiliyor mu?Tetra çeşitleri ve 1 çift cüce çikletim var akvaryumumda...Ölçülerim 50x50x50 cm[/QUOTE]
Killifish (Gardneri) sonrası başka balık (tetra) bakmak istemeyecesiniz.
Nsukka ve Jos plateau iki varyete mevcut.
Tüm killifish türleri kısıtlı ömre ve inanılmaz bir üreme arzusuna sahipler.
Her kurulum için 2e 4d uygun olmakta.
Azgın bireyi ayırmak için hazırlıklı olmakta gerekli.
Canlılarım
- Betta krataios Betta Dimidiata - Firefly
- Betta rubra Betta Rubra
- Betta rubra Betta Rubra
- Tateurndina ocellicauda (Tavuskuşu Gobi) Tateurndina Ocellicauda (tavuskuşu Gobi)
- Fundulopanchax gardneri gardneri (Gardneri Killifish - Yıllık Balığı) Fundulopanchax Gardneri
- Betta macrostoma (Brunei Güzeli) Betta Macrostoma
- Tanichthys albonubes (Kardinal Balığı) Tanichthys Albonubes (kardinal Balığı)
- Poecilocharax weitzmani (Siyah Fırlayan Tetra) Poecilocharax Weitzmani - Black Darter Tetra
- Tateurndina ocellicauda (Tavuskuşu Gobi) Tateurndina Ocellicauda - Tavuskuşu Gobi
- Rineloricaria sp. (Kırmızı Kertenkele Kedibalığı - L010A) L10 Red Lizard
- Trichogaster leerii (İnci Gurami) Inci Gurami - Trichogaster Leerii
- Nothobranchius guentheri Nothobranchius Guentheri Zanzibar
- Limia nigrofasciata (Kambur Limia) Limia Nigrofasciata - Humpback Limia
- Cambarellus patzcuarensis (Meksika Cüce Portakal Kereviti) Cambarellus Diminutus
- Dermogenys pusillus (Halfbeak) Halfbeak Platinum - Dermogenys Pusillus
- Betta pi Betta Simorum
- Betta simplex Betta Simplex
- Parosphromenus deissneri (Meyankökü Gurami) Parosphromenus Deissneri
- Sphaerichtys vaillanti (Samuray Gurami) Sphaerichtys Vaillanti
- Betta persephone Betta Persephone
- Nothobranchius guentheri Nothobranchius Guentheri Zanzibar
- Carinotetraodon travancoricus (Pigme Puffer) Carinotetraodon Travancoricus - Pigme Puffer
- Macropodus opercularis (Cennet Balığı) Macropodus Opercularis (cennet Balığı)
- Oryzias latipes (Japanese Rice Fish, Japon Pirinç Balığı) Medaka Japon Pirinç Balığı (oryzias Latipes)
- Betta albimarginata Betta Albimarginata
- Dario dario (Kırmızı Badis) Dario Dario- Red Scarlet
- Rineloricaria sp. (Kırmızı Kertenkele Kedibalığı - L010A) Rineloricaria - Red Lizard L010a
- Danio margaritatus (Gök İncisi Danio - Galaxy Rasbora) Danio Margaritatus-galaxy Rasbora
- Oryzias latipes (Japanese Rice Fish, Japon Pirinç Balığı) Oryzias Latipes (medaka)
- Hyphessobrycon flammeus Tetra Üretim Güncesi
- Danio margaritatus (Gök İncisi Danio - Galaxy Rasbora) Galaxy Rasbora